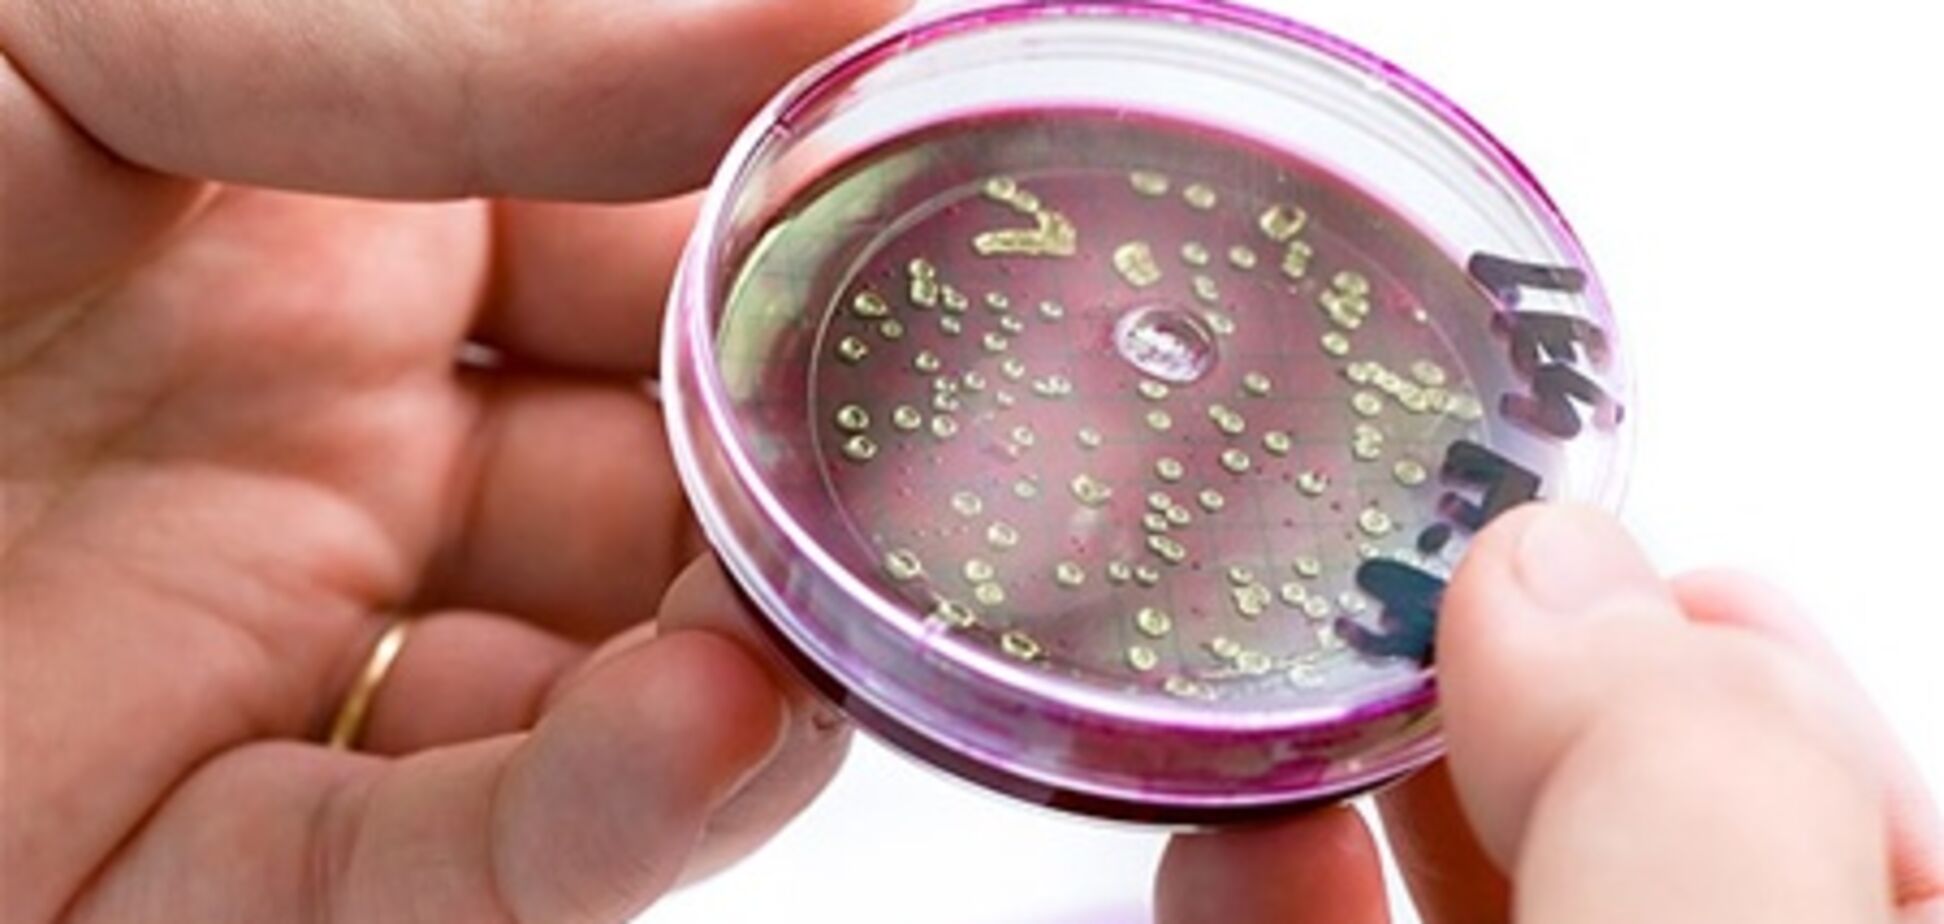
Кишкова паличка E.coli передається від людини до людини
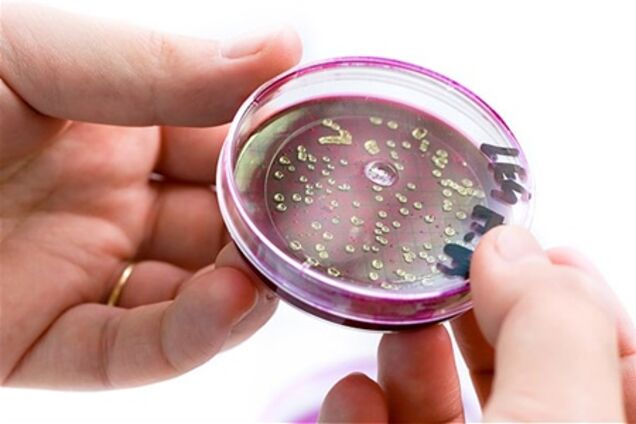
Кишкова паличка E.coli передається від людини до людини

Кишкова паличка E.coli передається від людини до людини
Глава МОЗ Німеччини Даніель Бар повідомив, що кишкова паличка E.coli, яка викликає смертельно небезпечне інфекційне захворювання, передається від людини до людини. За його словами, медики довели, що в Гессені 20 осіб заразилися кишковою інфекцією від співробітниці компанії виїзного ресторанного обслуговування. Сама вона підхопила бактерію, з'ївши заражені паростки сої. А через кілька днів "передала" її клієнтам ресторану, працюючи над виготовленням замовлених страв для сімейної вечірки.
В Європі від кишкової інфекції, викликаної бактерією E.coli, загинуло вже понад 50 чоловік. Число тих, що заразилися кишковою паличкою в Європі, перевищило 4 тис. осіб. Небезпечна кишкова інфекція в Європі спочатку була зафіксована на півночі Німеччини. Спочатку експерти вважали, що джерелом хвороби стали імпортовані з Іспанії огірки, помідори і салат. Випадки інфекції зафіксовані в 12 країнах.










